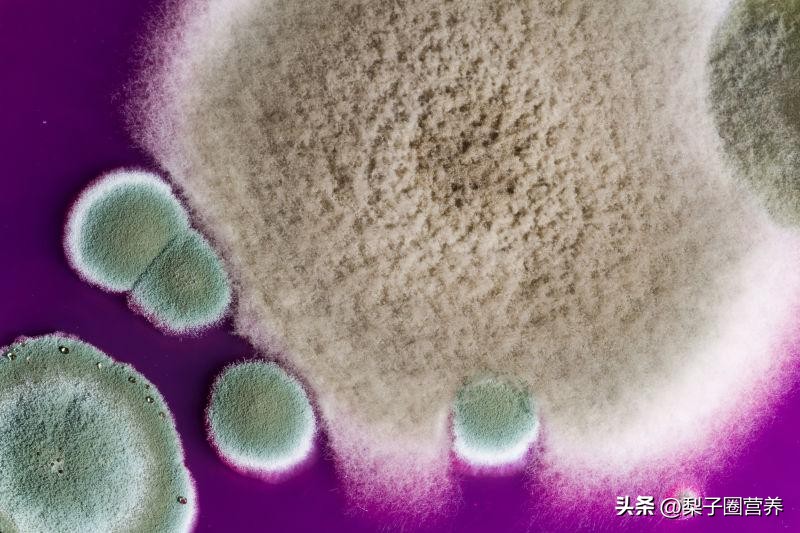
警惕这种水果比毒蛇还毒,警惕这种剧毒千万别拿来煲汤

天气转暖,也到了各种病菌繁殖的季节。甘蔗,是老少皆宜的可口美食,但是“清明蔗,毒过蛇”,你是否听说过呢?其实,网络上不乏吃甘蔗中毒的报道。

原因及危害
霉变甘蔗中毒常发生在我国北方地区的初春季节,2-3月份为发病高峰期。甘蔗霉变主要是因为甘蔗的长期储存,比如过冬,导致微生物大量繁殖,其中一种叫甘蔗节菱孢霉的真菌,是引起甘蔗中毒的主要原因。甘蔗新鲜时,这种病菌的污染率仅为 0.7%-1.5% ,经过3个月的储藏,污染率可达到 34%-56% 。曾经一项针对上海地区41份甘蔗样品的研究,发现检出节菱孢的甘蔗占12.2%。
甘蔗节菱孢霉产生的3-硝基丙酸是一种强烈的嗜神经毒素,损害中枢神经系统。最短十几分钟,中毒中毒者多在两小时内发病。中毒最初表现为消化道功能紊乱,表现为恶心、呕吐、腹泻、腹痛、黑便,随后出现头晕、头痛等神经系统症状,重度可发生抽搐(手呈鸡爪状、眼球向上、瞳孔散大),甚至昏迷。可死于呼吸衰竭,幸存者留下严重的神经系统后遗症,导致终生残疾。

不同于蛇毒,甘蔗节菱孢霉中毒后没有特效的解毒药,只能进行洗胃、灌肠等进行排毒,并对症处理。因此,防止中毒的唯一途径就是不食用霉变甘蔗。
如何识别霉变甘蔗
霉变甘蔗的与正常甘蔗的差别很大,还是非常好区分。霉变甘蔗的质地较软,瓤部的色泽比正常深,呈浅棕色。购买甘蔗时,最好现卖现削,防止不良商贩将霉变部分去掉,当成正常甘蔗售卖。购买的甘蔗尽快食用,不能放置过久,发现有颜色、质地或者气味的变化,要坚决丢弃,可不能因小失大哦。

赶快看看你家买的甘蔗是否有霉变吧!
关注梨子圈营养,一起成为博学的吃货!欢迎点赞、评论和转发哦!
部分图片来源于网络,侵删!